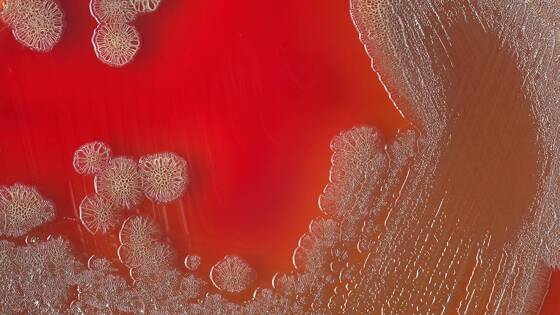

Ученые предупредили о трех болезнях, способных уничтожить все человечество
Некоторые болезни, в том числе менингококк, некротические пятна и холера, при определенных обстоятельствах могут стать причиной вымирания всего человечества. К такому выводу пришли ученые.
По мнению экспертов, менингококк представляет для людей серьезную опасность. Инфекционное заболевание на ранних стадиях напоминает ОРВИ, при этом оно стремительно нарушает работу организма всего за несколько часов. Заразившийся патогеном человек может умереть за пару дней, поскольку менингококк легко перерастает в менингит и поражает головной мозг.
Некротические пятна — бактериальная инфекция, которая обычно поражает организм после пищевого отравления. По течению болезнь напоминает грипп. Однако при отсутствии незамедлительного лечения некротические пятна убивают в считаные дни.
Не меньшую опасность представляет острая кишечная инфекция под названием холера. Человек может заразиться ей, если выпьет грязную воду или съест инфицированные продукты питания. Иногда заразившийся умирает от болезни за несколько часов, передает «МедиаПоток».
В Таиланде и Мьянме произошла вспышка холеры. За последний месяц в приграничном городе Шве Кокко зарегистрировали около 300 случаев этого заболевания. На территории России эпидемиологическая ситуация по холере стабильна. Что это за заболевание и как избежать заражения, выясняла «Вечерняя Москва».